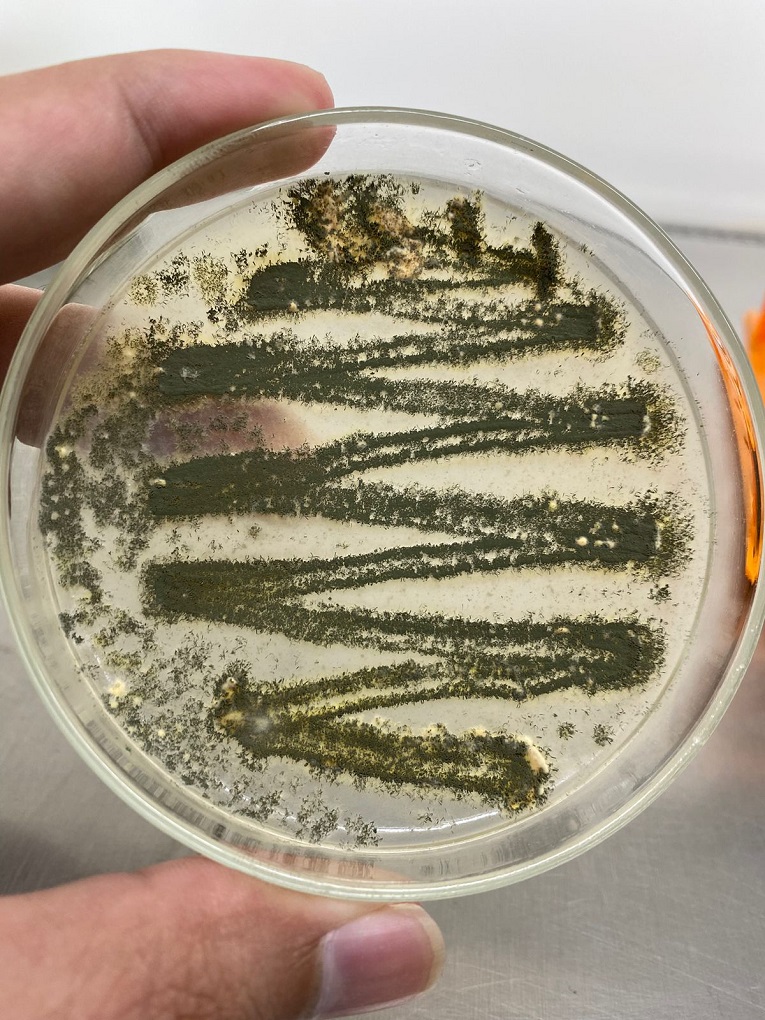

Três tecnologias inovadoras – e brasileiras – de combate à dengue
Fungos amazônicos, análise preditiva de mosquitos e drones anti-insetos são tecnologias que podem tirar a epidemia do calendário de tragédias nacionais

Baseadas em conhecimentos da Amazônia, em dados preditivos e em análise comportamental de insetos, startups brasileiras criam novas maneiras para o país enfrentar o Aedes aegypti e a dengue.
Com muito apoio científico – mas ainda pouco investimento financeiro –, elas dão fôlego para o Brasil numa batalha longa e extenuante contra surtos cada vez mais mortais da doença.
Os números de 2024 mostram o tamanho da guerra que ainda precisamos vencer. Só até o final de março, foram mais de 1,8 milhão de casos de dengue no Brasil, com um pouco mais de 1,5 mil mortes confirmadas da doença. Com isso, já ultrapassamos o número total de casos que tivemos durante todo o ano de 2023 (1,6 milhão). É a maior epidemia de dengue da história do país.
O surto do vírus atingiu a América Latina. Já são mais de 4,6 milhões de casos até o começo de abril, no que a Organização Mundial de Saúde chama de “pior surto da história”.

Dois fatores explicam o surto sem precedentes: o fortalecimento dos mosquitos e o caos climático. Tais elementos tendem a piorar nos próximos anos.
“Desde 1991, tivemos apenas dois anos em que não houve epidemia de dengue. Se acontece com tanta frequência, é porque tem algo errado na forma como lidamos com o mosquito”, diz Davi dos Santos Luca, fundador da startup Ondaedes, que disponibiliza uma ferramenta de previsão e prevenção de arboviroses.
Especialista em ciência de dados e geomarketing, Lucas levantou anos de dados epidemiológicos, climáticos e populacionais para criar uma plataforma de comportamento preditivo do Aedes aegypti. Assim, o pesquisador traçou o perfil dos mosquitos que se espalham no Brasil e descobriu peculiaridades.

Os ovos dos insetos, por exemplo, eclodem mais rapidamente em temperaturas de superfície acima dos 40ºC, diferente do que mostra a literatura científica, que aponta o valor como a “marca” para a reprodução dos mosquitos diminuir. Com a mudança de temperatura no planeta, a tendência é que os mosquitos fiquem ainda mais resistentes a intempéries.
Além dos fatores externos, há a questão genética. De acordo com Ricardo Machado, fundador da Birdview, especializada em biocontrole de pragas, a resistência à dedetização é passada de geração para geração. O problema é que os ciclos são muito curtos.

O Aedes aegypti passa de larva para fase adulta em 45 dias. Nesse período, as fêmeas conseguem colocar 450 ovos. A cada vez que se reproduzem, os insetos passam “melhorias” genéticas com o objetivo de manter a espécie viva. O que significa que eles aprendem formas de escapar de pesticidas e repelentes. E esses produtos deixam de fazer efeito com o tempo – o que temos sentido na pele.
“O fumacê vem perdendo a eficácia a cada ano e causando resistência no aedes”, afirma Luca.
Dados os dois desafios, as startups brasileiras procuram formas de não só monitorar, mas impedir que o mosquito evolua a ponto de se tornar um “supermosquito”. “É um temor parecido com o que o mundo médico tem das superbactérias”, aponta Machado.
DIRETO DO SOLO DA AMAZÔNIA
Uma das maneiras mais extraordinárias de se combater o Aedes aegypti veio da terra da Amazônia. Literalmente. Espécies de fungos encontradas em solo amazônico têm função inseticida e são capazes de matar larvas de mosquitos em menos de quatro dias.
Um dos descobridores desse poder foi Gleison Rafael Mendonça, fundador da MetAttack, startup de biotecnologia para inseticidas biológicos. Fundada em Rio Branco, no Acre, a startup de Mendonça é fruto de mais de 10 anos de pesquisa do cientista no chão da floresta.
“Se existe um organismo versátil no mundo, está no reino Fungi”, diz Mendonça. Desde 2018, o cientista pesquisa como os fungos podem ser usados como inseticidas contra o Aedes Aegypti. O que o motiva é testemunhar a alta mortalidade de doenças ligadas ao mosquito no Acre a cada ano.
Dois fatores explicam o surto sem precedentes: o fortalecimento dos mosquitos e o caos climático.
Em 2021, por exemplo, o Estado teve surto de dengue e aumento de casos de chikungunha enquanto estava lidando com a pandemia de Covid-19, o que levou a rede de saúde pública ao colapso. Por lá, a falta de eficiência dos inseticidas afeta a maneira com que as autoridades lidam com o mosquito.
Segundo o pesquisador, a maioria dos produtos usados para espantar o Aedes aegypti não funciona na Amazônia devido à umidade e às condições climáticas da região. Nesse sentido, as duas espécies de fungos se tornam ainda mais importantes. Até o desenvolvimento do produto da MetAttack, não existia um inseticida 100% amazônico, com base nesse bioma.
As espécies pesquisadas por Mendonça já são usadas atualmente na indústria agrícola para prevenção de pragas e poderiam ser usadas por grupos de controle de saúde. O que o cientista faz é isolá-las e induzir o crescimento dos fungos no laboratório. “Eles têm boa resposta tanto no meio ambiente quanto no espaço controlado de laboratório”, garante.
No momento que é colocado em contato com a água, o fungo lança esporos inseticidas, capazes de matar 100% das larvas. Tudo isso sem o risco de ser mais um deposto químico no meio ambiente. Mendonça pesquisa a possível ação contra os ovos.
Ainda em fase de aprovação junto a agências ambientais e à Agência Nacional de Vigilância Sanitária (Anvisa), o produto da MetAttack passa por outro desafio: o financeiro. “Toda essa fase de autorização requer bastante recurso. Estamos buscando investimento, participando de eventos que propiciem contatos com investidores.”
Mendonça lembra que, embora o setor de biotecnologia esteja crescendo no Acre, ainda há pouco olhar de investidores para a região.
COMO UM AEDES AGIRIA?
Os fungos da MetAttack são apenas uma parte de uma solução para acabar com a dengue. É preciso entender em que espaços distribuí-los para que, de fato, o maior número de larvas sejam exterminadas. E é aí que entra a Ondaedes, de Davi Luca.
O sistema foi criado em Vitória da Conquista, na Bahia, para entender porque a cidade teve um surto da doença tão mortal em 2019, apesar das condições não serem consideradas favoráveis a esse tipo de fenômeno. Davi Luca fez uma plataforma de big data, unindo dados geolocalizados que pudessem explicar a alta de casos na cidade.
as startups procuram formas de impedir que o mosquito evolua a ponto de se tornar um “supermosquito”.
O que encontrou foi uma forma de rastrear as populações de Aedes aegypti, já que conseguiu entender como eles se comportam nos municípios brasileiros. A Ondaedes cruza informações da localização dos casos, da temperatura da superfície, da incidência de chuvas, do tipo de adensamento populacional e do formato das moradias e cria um mapa de calor.
Nesse mapa, é possível observar quais áreas têm mais tendência de ter circulação de mosquitos infectados e quais podem ser afetadas. Também aponta quais as regiões da cidade que podem ter mais ovos, ajudando a ação dos agentes de saúde.
Outro dado que a plataforma de Luca mostra é a circulação de pessoas. “Os mosquitos picam em um período, e a gente analisa quais áreas da cidade têm mais circulação nesse período. Entender isso pode apoiar o município a visualizar e prever os bairros que precisam de mais cuidado”, explica.
Dados como a quantidade de mulheres grávidas na região também apoiam a ação de prefeituras contra o zika vírus, causador de microcefalia.
A startup está em conversas com governos municipais e com países europeus. A ideia é o produto chegar em uma segunda fase para passar a também servir para o usuário final. “Queremos criar um aplicativo ou um sistema de alerta que avise as pessoas sobre as regiões mais afetadas onde elas devem se proteger contra o mosquito.”
A SALVAÇÃO VEM PELO AR (E PARECE UM MOSQUITO)
E se os mosquitos pararem de se reproduzir? Esta é a saída escolhida pela BirdView. A startup da cidade de São Manuel, no interior paulista, tem especialidade em bioinseticidas para o mercado agrícola. A companhia usa drones para chegar em espaços remotos de lavouras.
De acordo com o CEO da companhia, Ricardo Machado, insetos e outros animais pequenos (ou bioinseticidas) controlam a infestação de pragas em lavouras. Fundada em 2015, a startup começou a analisar como usar as soluções para reduzir a reprodução do Aedes aegypti e encontrou uma alternativa: soltar mosquitos estéreis na natureza.
A tecnologia usa raios-X para “castrar” mosquitos machos. Os insetos são lançados no meio ambiente, cruzam com os selvagens e interrompem o ciclo dos ovos, já que não há fertilização. “A técnica evita que os mosquitos criem mais resistências genéticas”, explica Machado.

Para espalhar os bichinhos estéreis, a companhia usa drones. Um drone pequeno tem capacidade de fazer a soltura de 17 mil insetos por voo e cobre uma área de 100 mil metros quadrados. “Com os drones, conseguimos soltar os mosquitos machos em áreas urbanas remotas, como terrenos baldios”, diz o executivo.
A companhia trabalha em conjunto com a Empresa Brasileira de Agropecuária (Embrapa) e com a Organização das Nações Unidas (ONU). Além de agir contra o Aedes aegypti, a técnica dos insetos inférteis funciona contra a mosca tsé-tsé, que espalha a “doença do sono” em solo africano.
A startup está em discussão com prefeituras e secretarias estaduais de saúde com o objetivo de assinar contratos antes do final deste ano. Considerando o surto da dengue atual e os próximos que podem vir, as ações são mais do que urgentes.